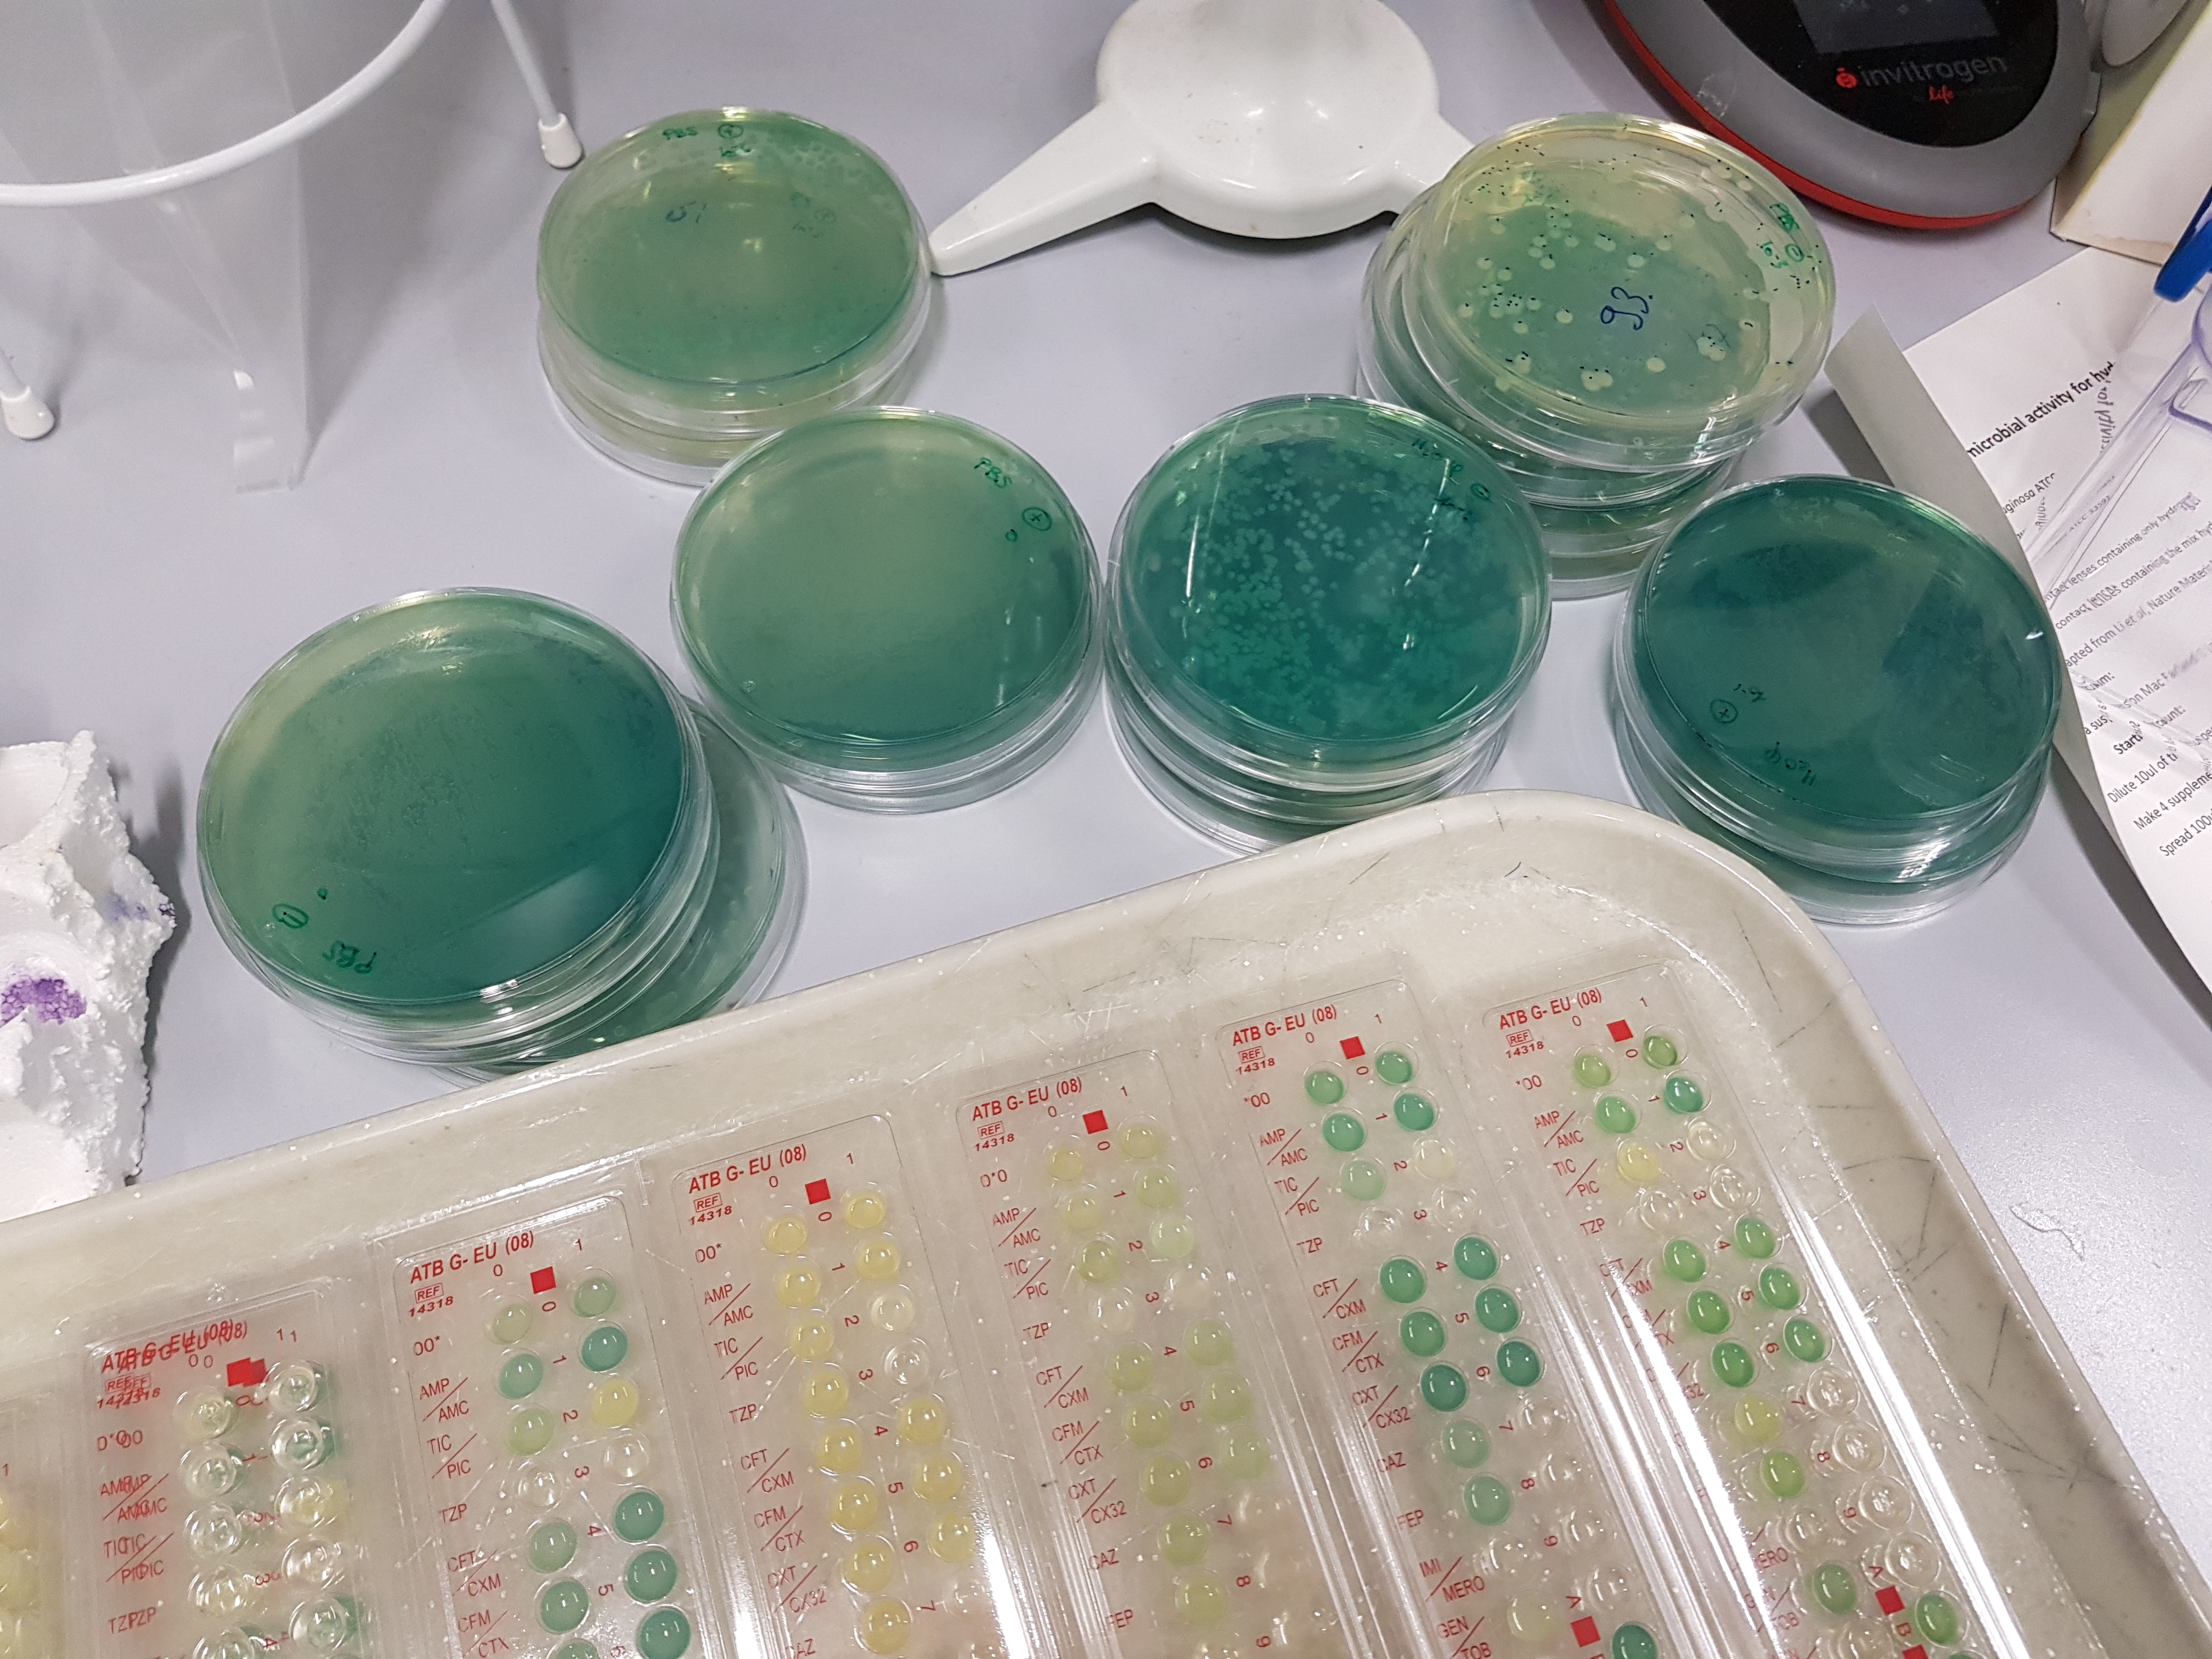
20170522_203529.jpg

Our research explores the role of zinc (Zn) and copper (Cu) in bacterial physiology, particularly in Pseudomonas aeruginosa, an opportunistic pathogen responsible for severe infections. We study how exposure to these metals — in polluted environments or within the host during phagocytosis — influences:
These studies aim to better understand the connections between metals, antimicrobial resistance, and pathogenicity.

This research axis encompasses our applied projects focused on developing innovative solutions to combat bacterial infections. Our approaches span several complementary directions: